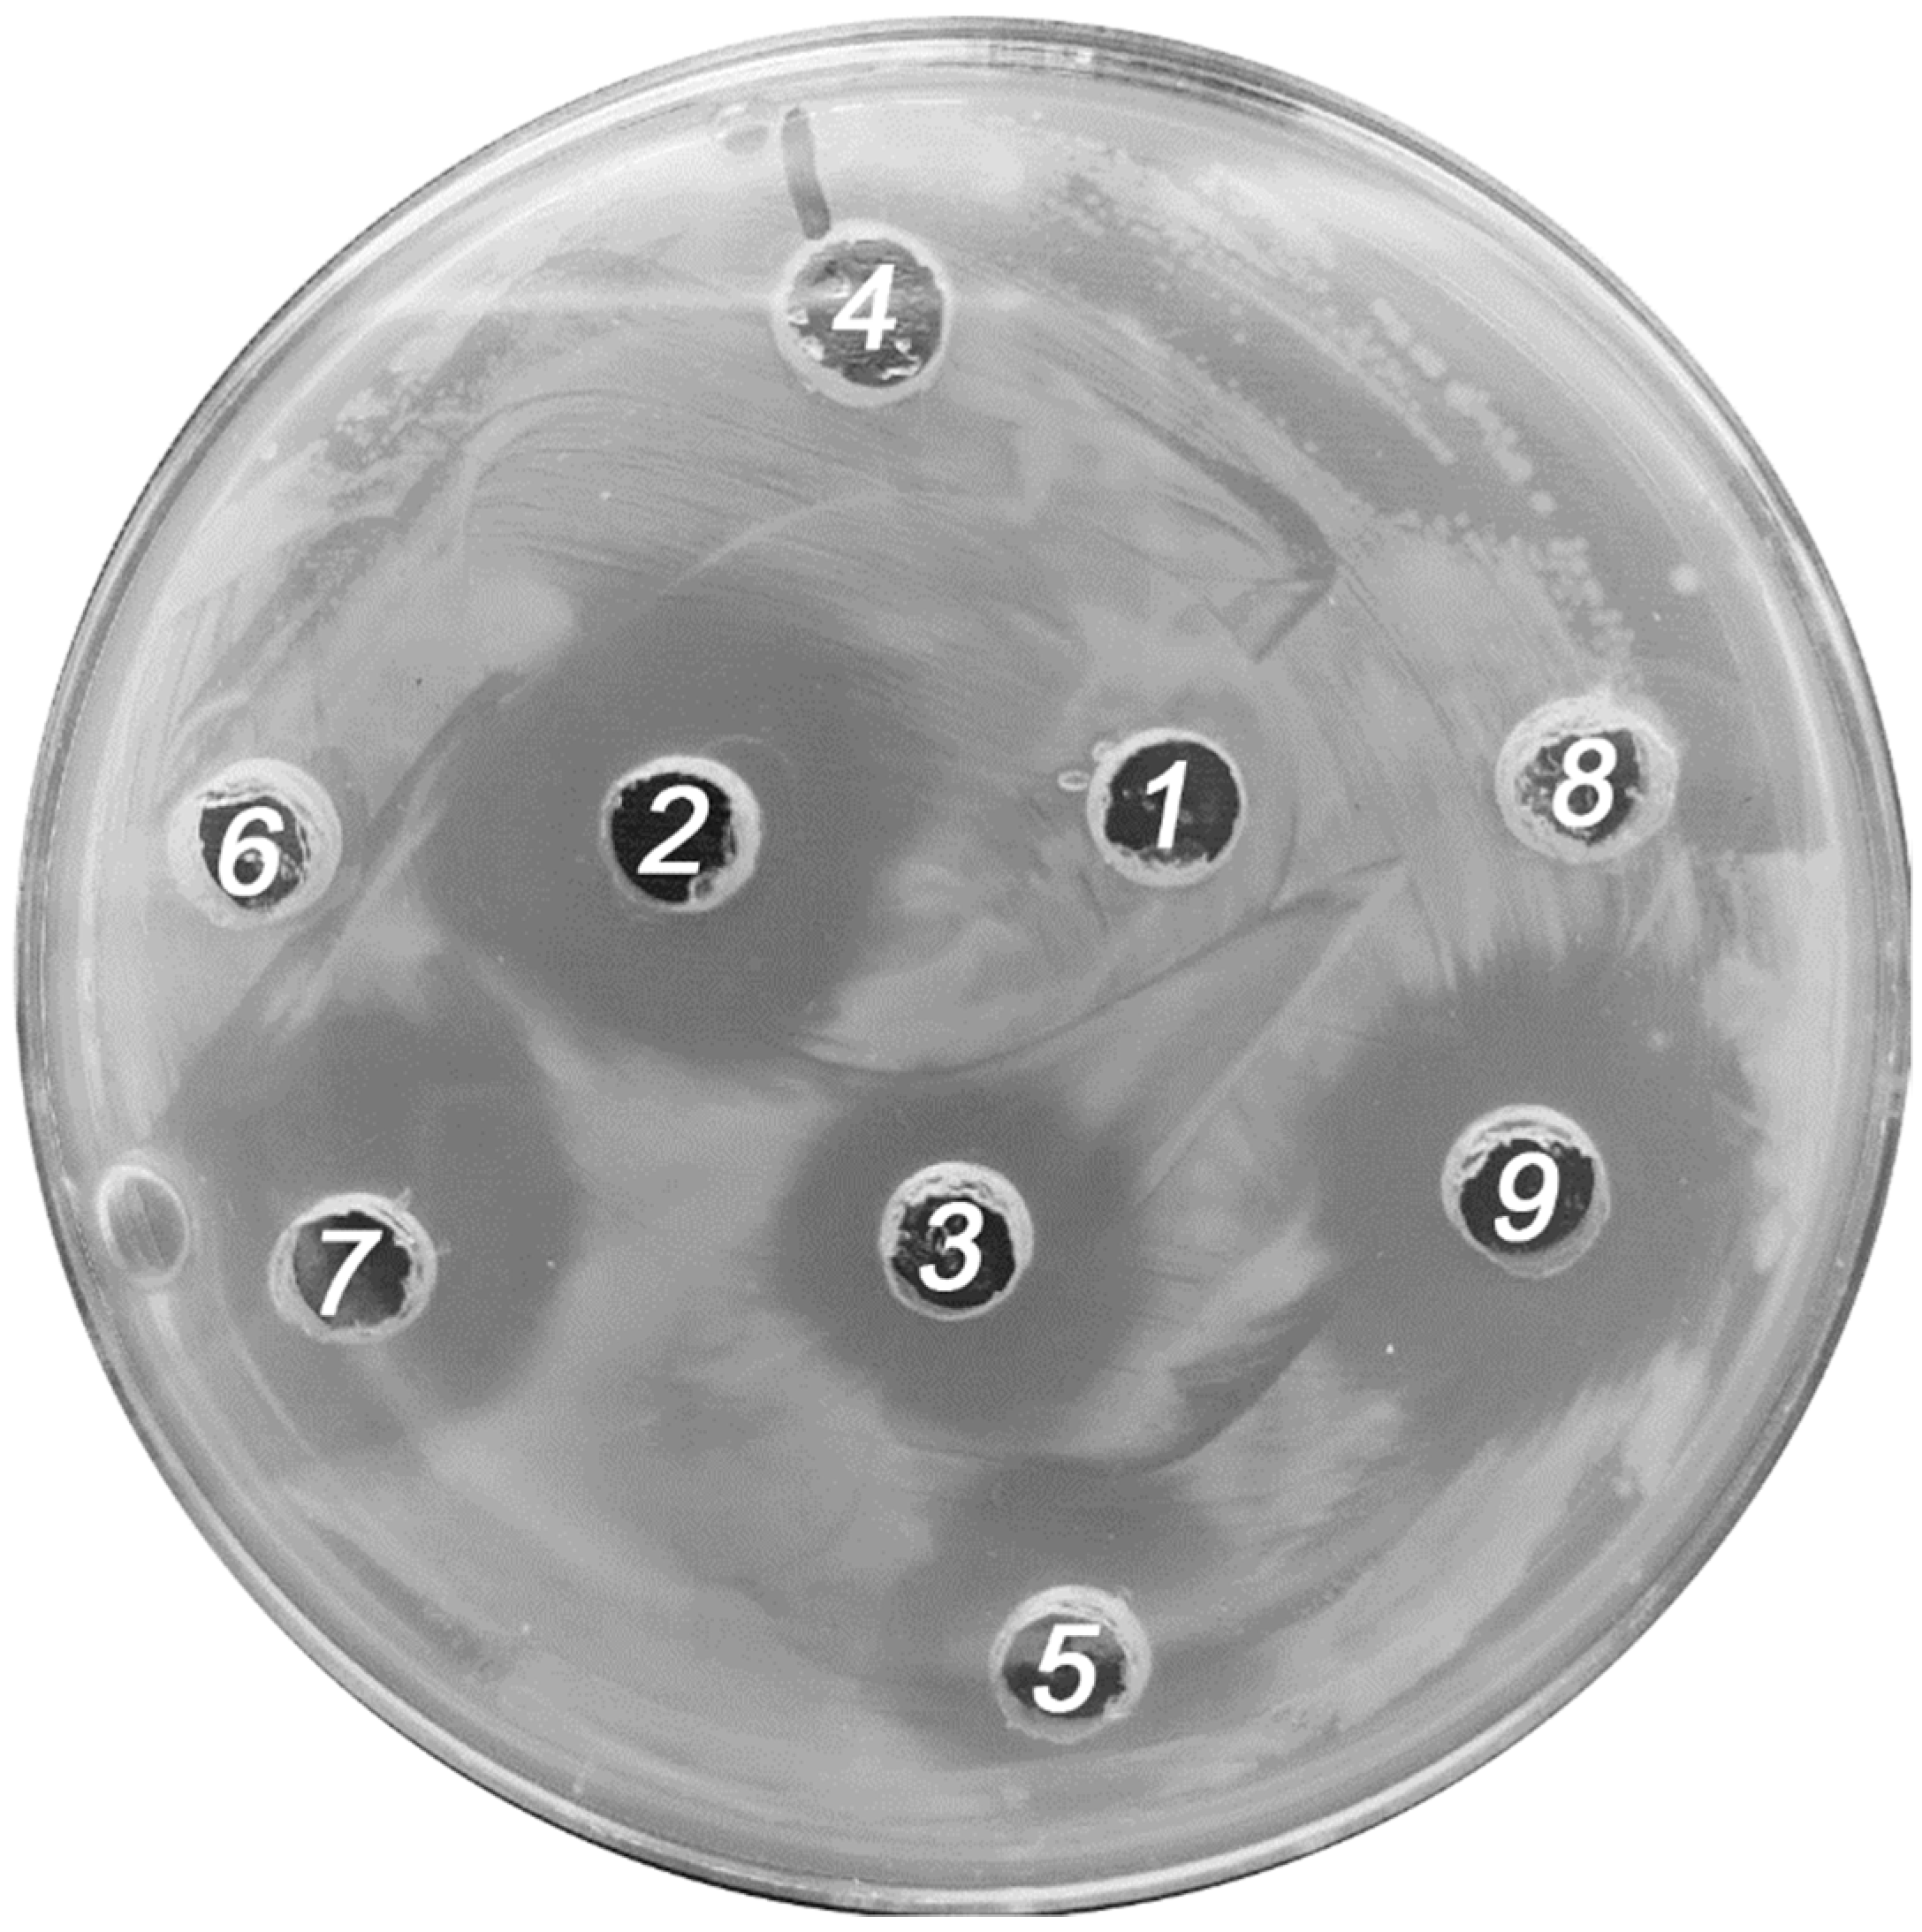
Inorganics 11 00009 g005

Association of Keplerate-Type Polyoxometalate {Mo72Fe30} with Tetracycline: Nature of Binding Sites and Antimicrobial Action
Abstract
1. Introduction
2. Results and Discussion
3. Materials and Methods
4. Conclusions
Author Contributions
Funding
Institutional Review Board Statement
Informed Consent Statement
Data Availability Statement
Conflicts of Interest
References
- Müller, A.; Krickemeyer, E.; Meyer, J.; Bögge, H.; Peters, F.; Plass, W.; Diemann, E.; Dillinger, S.; Nonnenbruch, F.; Randerath, M.; et al. [Mo154(NO)14O420(OH)28(H2O)70](25 ± 5)−: A Water-Soluble Big Wheel with More than 700 Atoms and a Relative Molecular Mass of About 24000. Angew. Chem. Int. Ed. Engl. 1995, 34, 2122–2124. [Google Scholar] [CrossRef]
- Müller, A.; Krickemeyer, E.; Bögge, H.; Schmidtmann, M.; Peters, F. Organizational Forms of Matter: An Inorganic Super Fullerene and Keplerate Based on Molybdenum Oxide. Angew. Chem. Int. Ed. 1998, 37, 3359–3363. [Google Scholar] [CrossRef]
- Müller, A.; Sarkar, S.; Shah, S.Q.N.; Bögge, H.; Schmidtmann, M.; Sarkar, S.; Kögerler, P.; Hauptfleisch, B.; Trautwein, A.X.; Schünemann, V. Archimedean Synthesis and Magic Numbers: “Sizing” Giant Molybdenum-Oxide-Based Molecular Spheres of the Keplerate Type. Angew. Chem. Int. Ed. 1999, 38, 3238–3241. [Google Scholar] [CrossRef]
- Ostroushko, A.A.; Safronov, A.P.; Tonkushina, M.O. Thermochemical Study of Interaction between Nanocluster Polyoxomolybdates and Polymers in Film Compositions. Russ. J. Phys. Chem. A 2014, 88, 295–300. [Google Scholar] [CrossRef]
- Grzhegorzhevskii, K.V.; Tonkushina, M.O.; Fokin, A.V.; Belova, K.G.; Ostroushko, A.A. Coordinative Interaction between Nitrogen Oxides and Iron–Molybdenum POM Mo 72 Fe 30. Dalt. Trans. 2019, 48, 6984–6996. [Google Scholar] [CrossRef]
- Grzhegorzhevskii, K.V.; Denikaev, A.D.; Morozova, M.V.; Pryakhina, V.; Khairullina, E.; Tumkin, I.; Taniya, O.; Ostroushko, A.A. The Precise Modification of a Nanoscaled Keplerate-Type Polyoxometalate with NH 2 -Groups: Reactive Sites, Mechanisms and Dye Conjugation. Inorg. Chem. Front. 2022, 9, 1541–1555. [Google Scholar] [CrossRef]
- Fazylova, V.; Shevtsev, N.; Mikhailov, S.; Kim, G.; Ostroushko, A.; Grzhegorzhevskii, K. Fundamental Aspects of Xanthene Dye Aggregation on the Surfaces of Nanocluster Polyoxometalates: H- to J-Aggregate Switching. Chem. A Eur. J. 2020, 26, 5685–5693. [Google Scholar] [CrossRef]
- Ostroushko, A.; Gagarin, I.; Tonkushina, M.; Grzhegorzhevskii, K.; Russkikh, O. Association of Spherical Porous Nanocluster Keplerate-Type Polyoxometalate Mo72Fe30 with Biologically Active Substances. J. Clust. Sci. 2018, 29, 111–120. [Google Scholar] [CrossRef]
- Tonkushina, M.O.; Belozerova, K.A.; Gagarin, I.D.; Adamova, L.V.; Terziyan, T.V.; Russkikh, O.V.; Ostroushko, A.A. Thermodynamics of the Interaction between Keplerate-Type Polyoxometalate {Mo72Fe30} and Vitamin B1. Thermochim. Acta 2022, 711, 179201. [Google Scholar] [CrossRef]
- Elistratova, J.; Akhmadeev, B.; Gubaidullin, A.; Korenev, V.; Sokolov, M.; Nizameev, I.; Stepanov, A.; Ismaev, I.; Kadirov, M.; Voloshina, A.; et al. Nanoscale Hydrophilic Colloids with High Relaxivity and Low Cytotoxicity Based on Gd(Iii) Complexes with Keplerate Polyanions. New J. Chem. 2017, 41, 5271–5275. [Google Scholar] [CrossRef]
- Ostroushko, A.A.; Danilova, I.G.; Gette, I.F.; Medvedeva, S.Y.; Tonkushina, M.O.; Prokofieva, A.V.; Morozova, M.V. Study of Safety of Molybdenum and Iron-Molybdenum Nanoclaster Polyoxometalates Intended for Targeted Delivery of Drugs. J. Biomater. Nanobiotechnol. 2011, 2, 557–560. [Google Scholar] [CrossRef]
- Ostroushko, A.A.; Gagarin, I.D.; Grzhegorzhevskii, K.V.; Gette, I.F.; Vlasov, D.A.; Ermoshin, A.A.; Antosyuk, O.N.; Shikhova, S.V.; Danilova, I.G. The Physicochemical Properties and Influence on Living Organisms of Nanocluster Polyoxomolybdates as Prospective Bioinspired Substances (Based on Materials from the Plenary Lecture). J. Mol. Liq. 2020, 301, 110910. [Google Scholar] [CrossRef]
- Ostroushko, A.A.; Gagarin, I.D.; Tonkushina, M.O.; Grzhegorzhevskii, K.V.; Danilova, I.G.; Gette, I.F.; Kim, G.A. Iontophoretic Transport of Associates Based on Porous Keplerate-Type Cluster Polyoxometalate Mo72Fe30 and Containing Biologically Active Substances. Russ. J. Phys. Chem. A 2017, 91, 1811–1815. [Google Scholar] [CrossRef]
- Ostroushko, A.A.; Grzhegorzhevskii, K.V.; Medvedeva, S.Y.; Gette, I.F.; Tonkushina, M.O.; Gagarin, I.D.; Danilova, I.G. Physicochemical and Biochemical Properties of the Keplerate-Type Nanocluster Polyoxomolybdates as Promising Components for Biomedical Use. Nanosyst. Phys. Chem. Math. 2021, 12, 81–112. [Google Scholar] [CrossRef]
- Ostroushko, A.A.; Ulitko, M.V.; Tonkushina, M.O.; Zubarev, I.V.; Medvedeva, S.Y.; Danilova, I.G.; Gubaeva, O.V.; Gagarin, I.D.; Gette, I.F. Influence of Nanocluster Molybdenum Polyoxometalates on the Morphofunctional State of Fibroblasts in Culture. Nanotechnol. Russ. 2018, 13, 1–10. [Google Scholar] [CrossRef]
- Karthikeyan, G.; Mohanraj, K.; Elango, K.P.; Girishkumar, K. Synthesis, Spectroscopic Characterization and Antibacterial Activity of Lanthanide–Tetracycline Complexes. Transit. Met. Chem. 2004, 29, 86–90. [Google Scholar] [CrossRef]
- Wang, H.; Yao, H.; Sun, P.; Li, D.; Huang, C.-H. Transformation of Tetracycline Antibiotics and Fe (II) and Fe (III) Species Induced by Their Complexation. Environ. Sci. Technol. 2016, 50, 145–153. [Google Scholar] [CrossRef]
- Guerra, W.; Silva-Caldeira, P.P.; Terenzi, H.; Pereira-Maia, E.C. Impact of Metal Coordination on the Antibiotic and Non-Antibiotic Activities of Tetracycline-Based Drugs. Coord. Chem. Rev. 2016, 327–328, 188–199. [Google Scholar] [CrossRef]
- Liu, T.; Imber, B.; Diemann, E.; Liu, G.; Cokleski, K.; Li, H.; Chen, Z.; Müller, A. Deprotonations and Charges of Well-Defined {Mo 72 Fe 30} Nanoacids Simply Stepwise Tuned by PH Allow Control/Variation of Related Self-Assembly Processes. J. Am. Chem. Soc. 2006, 128, 15914–15920. [Google Scholar] [CrossRef]
- Izzet, G.; Ménand, M.; Matt, B.; Renaudineau, S.; Chamoreau, L.M.; Sollogoub, M.; Proust, A. Cyclodextrin-Induced Auto-Healing of Hybrid Polyoxometalates. Angew. Chem. Int. Ed. 2012, 51, 487–490. [Google Scholar] [CrossRef]
- Assaf, K.I.; Ural, M.S.; Pan, F.; Georgiev, T.; Simova, S.; Rissanen, K.; Gabel, D.; Nau, W.M. Water Structure Recovery in Chaotropic Anion Recognition: High-Affinity Binding of Dodecaborate Clusters to γ-Cyclodextrin. Angew. Chem. Int. Ed. 2015, 54, 6852–6856. [Google Scholar] [CrossRef] [PubMed]
- Falaise, C.; Khlifi, S.; Bauduin, P.; Schmid, P.; Shepard, W.; Ivanov, A.A.; Sokolov, M.N.; Shestopalov, M.A.; Abramov, P.A.; Cordier, S.; et al. “Host in Host” Supramolecular Core–Shell Type Systems Based on Giant Ring-Shaped Polyoxometalates. Angew. Chem. Int. Ed. 2021, 60, 14146–14153. [Google Scholar] [CrossRef] [PubMed]
- Ivanov, A.A.; Falaise, C.; Shmakova, A.A.; Leclerc, N.; Cordier, S.; Molard, Y.; Mironov, Y.V.; Shestopalov, M.A.; Abramov, P.A.; Sokolov, M.N.; et al. Cyclodextrin-Assisted Hierarchical Aggregation of Dawson-Type Polyoxometalate in the Presence of {Re 6 Se 8} Based Clusters. Inorg. Chem. 2020, 59, 11396–11406. [Google Scholar] [CrossRef] [PubMed]
- Naskar, B.; Diat, O.; Nardello-Rataj, V.; Bauduin, P. Nanometer-Size Polyoxometalate Anions Adsorb Strongly on Neutral Soft Surfaces. J. Phys. Chem. C 2015, 119, 20985–20992. [Google Scholar] [CrossRef]
- Korenev, V.S.; Dorovatovskii, P.V.; Lazarenko, V.A.; Abramov, P.A.; Sokolov, M.N. Structural Features of Selenate Based {Mo 132} Keplerate Capsules. Cryst. Eng. Comm. 2022, 24, 321–329. [Google Scholar] [CrossRef]
- Grzhegorzhevskii, K.V.; Zelenovskiy, P.S.; Koryakova, O.V.; Ostroushko, A.A. Thermal Destruction of Giant Polyoxometalate Nanoclusters: A Vibrational Spectroscopy Study. Inorg. Chim. Acta 2019, 489, 287–300. [Google Scholar] [CrossRef]
- Ostroushko, A.A.; Tonkushina, M.O.; Safronov, A.P.; Korotaev, V.Y.; Vazhenin, V.A.; Kolosov, V.Y.; Martynova, N.A.; Kutyashev, I.B.; Bogdanov, S.G.; Pirogov, A.N.; et al. Study of the Stability of Solid Polyoxometalate Mo72Fe30 with a Buckyball Structure. Russ. J. Inorg. Chem. 2012, 57, 858–863. [Google Scholar] [CrossRef]
- Tonkushina, M.O.; Grzhegorzhevskii, K.V.; Ermoshin, A.A.; Tugbaeva, A.S.; Kim, G.A.; Taniya, O.S.; Gagarin, I.D.; Ostroushko, A.A. The Electrostatic-Mediated Formation of a Coordination Complex: The Trapping and Release of an Antitumor Drug with an Anthracycline Core from {Mo 72 Fe 30}-Based Ensembles. Chem. Sel. 2022, 7, e202203684. [Google Scholar] [CrossRef]
- Myers, H.M.; Tochon-Danguy, H.J.; Baud, C.A. IR Absorption Spectrophotometric Analysis of the Complex Formed by Tetracycline and Synthetic Hydroxyapatite. Calcif. Tissue Int. 1983, 35, 745–749. [Google Scholar] [CrossRef]
- Mohammed, O.F.; Xiao, D.; Batista, V.S.; Nibbering, E.T.J. Excited-State Intramolecular Hydrogen Transfer (ESIHT) of 1,8-Dihydroxy-9,10-Anthraquinone (DHAQ) Characterized by Ultrafast Electronic and Vibrational Spectroscopy and Computational Modeling. J. Phys. Chem. A 2014, 118, 3090–3099. [Google Scholar] [CrossRef]
- Bellamy, L.J. The Infra-Red Spectra of Complex Molecules; Springer: Dordrecht, The Netherlands, 1975; ISBN 978-94-011-6017-9. [Google Scholar]
- Cervini, P.; Machado, L.C.M.; Ferreira, A.P.G.; Ambrozini, B.; ÿder Cavalheiro, T.G. Thermal Decomposition of Tetracycline and Chlortetracycline. J. Anal. Appl. Pyrolysis 2016, 118, 317–324. [Google Scholar] [CrossRef]
- Filgueiras, A.L.; Paschoal, D.; Dos Santos, H.F.; Sant’Ana, A.C. Adsorption Study of Antibiotics on Silver Nanoparticle Surfaces by Surface-Enhanced Raman Scattering Spectroscopy. Spectrochim. Acta Part A Mol. Biomol. Spectrosc. 2015, 136, 979–985. [Google Scholar] [CrossRef] [PubMed]
- Gražulis, S.; Daškevič, A.; Merkys, A.; Chateigner, D.; Lutterotti, L.; Quirós, M.; Serebryanaya, N.R.; Moeck, P.; Downs, R.T.; Le Bail, A. Crystallography Open Database (COD): An Open-Access Collection of Crystal Structures and Platform for World-Wide Collaboration. Nucleic Acids Res. 2012, 40, D420–D427. [Google Scholar] [CrossRef] [PubMed]
- Krupodorova, T.A.; Barshteyn, V.Y.; Zabeida, E.F.; Pokas, E.V. Antibacterial Activity of Macromycetes Mycelia and Culture Liquid. Microbiol. Biotechnol. Lett. 2016, 44, 246–253. [Google Scholar] [CrossRef]

| {Mo72Fe30}@TC12.5 | Fe1-O1 | (Fe2)Ot-N+ | Fe3-Ot | Fe3-O3 | (Mo)Ot-H(amide) |
|---|---|---|---|---|---|
| 2.185 Å | 2.194 Å | 2.097 Å | 2.589 Å | 2.386–3.260 Å |
| Strain | Average Diameters of Sterile Zones (mm) for E. coli Strains | ||||||||
|---|---|---|---|---|---|---|---|---|---|
| TC | {Mo72Fe30} | MoVI | FeIII | DP | {Mo72Fe30}@TC12.5 | TC+MoVI | TC+FeIII | TC+DP | |
| HB101 | 8.3 ± 0.5 | 0.0 | 0.0 | 0.0 | 0.0 | 6.3 ± 0.5 | 7.3 ± 0.4 | 6.0 ± 0.4 | 6.2 ± 1.2 |
| JM110 | 7.7 ± 0.8 | 0.0 | 0.0 | 0.0 | 0.0 | 6.2 ± 0.8 | 7.5 ± 0.0 | 7.7 ± 0.7 | 4.8 ± 0.2 |
| ТОР10 | 6.7 ± 0.4 | 0.0 | 0.0 | 0.0 | 0.0 | 5.2 ± 0.2 | 5.5 ± 0.0 | 6.0 ± 0.0 | 6.2 ± 1.1 |
Disclaimer/Publisher’s Note: The statements, opinions and data contained in all publications are solely those of the individual author(s) and contributor(s) and not of MDPI and/or the editor(s). MDPI and/or the editor(s) disclaim responsibility for any injury to people or property resulting from any ideas, methods, instructions or products referred to in the content. |
© 2022 by the authors. Licensee MDPI, Basel, Switzerland. This article is an open access article distributed under the terms and conditions of the Creative Commons Attribution (CC BY) license (https://creativecommons.org/licenses/by/4.0/).
Share and Cite
Grzhegorzhevskii, K.; Tonkushina, M.; Gushchin, P.; Gagarin, I.; Ermoshin, A.; Belova, K.; Prokofyeva, A.; Ostroushko, A.; Novikov, A. Association of Keplerate-Type Polyoxometalate {Mo72Fe30} with Tetracycline: Nature of Binding Sites and Antimicrobial Action. Inorganics 2023, 11, 9. https://doi.org/10.3390/inorganics11010009
Grzhegorzhevskii K, Tonkushina M, Gushchin P, Gagarin I, Ermoshin A, Belova K, Prokofyeva A, Ostroushko A, Novikov A. Association of Keplerate-Type Polyoxometalate {Mo72Fe30} with Tetracycline: Nature of Binding Sites and Antimicrobial Action. Inorganics. 2023; 11(1):9. https://doi.org/10.3390/inorganics11010009
Chicago/Turabian StyleGrzhegorzhevskii, Kirill, Margarita Tonkushina, Pavel Gushchin, Ilya Gagarin, Alexander Ermoshin, Kseniya Belova, Anna Prokofyeva, Alexander Ostroushko, and Alexander Novikov. 2023. "Association of Keplerate-Type Polyoxometalate {Mo72Fe30} with Tetracycline: Nature of Binding Sites and Antimicrobial Action" Inorganics 11, no. 1: 9. https://doi.org/10.3390/inorganics11010009
APA StyleGrzhegorzhevskii, K., Tonkushina, M., Gushchin, P., Gagarin, I., Ermoshin, A., Belova, K., Prokofyeva, A., Ostroushko, A., & Novikov, A. (2023). Association of Keplerate-Type Polyoxometalate {Mo72Fe30} with Tetracycline: Nature of Binding Sites and Antimicrobial Action. Inorganics, 11(1), 9. https://doi.org/10.3390/inorganics11010009









